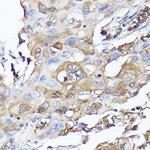
GBL Antibody in Immunohistochemistry (Paraffin) (IHC (P))

Search
Invitrogen
GBL Polyclonal Antibody
{{$productOrderCtrl.translations['antibody.pdp.commerceCard.promotion.promotions']}}
{{$productOrderCtrl.translations['antibody.pdp.commerceCard.promotion.viewpromo']}}
{{$productOrderCtrl.translations['antibody.pdp.commerceCard.promotion.promocode']}}: {{promo.promoCode}} {{promo.promoTitle}} {{promo.promoDescription}}. {{$productOrderCtrl.translations['antibody.pdp.commerceCard.promotion.learnmore']}}

Please note: We are reviewing Western blot images included in the antibody testing data in our catalog, including those provided by third parties. Unless expressly labeled or annotated as “raw-unedited”, Western blot images included in the antibody testing data in our catalog may have been edited, optimized or otherwise adjusted for presentation.
产品信息
PA5-89319
种属反应
宿主/亚型
分类
类型
抗原
偶联物
形式
浓度
规格
纯化类型
保存液
内含物
保存条件
运输条件
RRID
产品详细信息
Immunogen sequence: MNTSPGTVGS DPVILATAGY DHTVRFWQAH SGICTRTVQH QDSQVNALEV TPDRSMIAAA GYQHIRMYDL NSNNPNPIIS YDGVNKNIAS VGFHEDGRWM YTGGEDCTAR IWDLRSRNLQ CQRIFQVNAP INCVCLHPNQ AELIVGDQSG AIHIWDLKTD HNEQLIPEPE VSITSAHIDP DASYMAAVNS TGNCYVWNLT GGIGDEVTQL IPKTKIPAHT RYALQCRFSP DSTLLATCSA DQTCKIWRTS NFSLMTELSI KSGNPGESSR GWMWGCAFSG DSQYIVTASS DNLARLWCVE TGEIKREYGG HQKAVVCLAF NDSVLG; Positive Samples: 22Rv1, Mouse brain, Mouse thymus, Rat brain, Rat testis; Cellular Location: Cytoplasm
靶标信息
G-protein beta subunit like (GBL protein) is a novel member of WD-40 protein family. It is a highly conserved cytosolic protein consisting of seven WD-40 repeating motifs. LST8 is a functional component of mTOR signaling complex (TORC1) and positively up-regulates the mTOR pathway. It interacts with the kinase domain of mTOR and stabilizes its interaction with raptor. LST8 participates in regulating cell growth and also in nutrient and growth factor-mediated mTOR signaling to S6K1. Reports suggest up-regulated expression of LST8 due to insulin indicating a possible role of LST8 in intracellular events related to insulin-receptor activation including insulin-stimulated glucose transport and glycogen synthesis. Northern Blot analysis detected a ubiquitous expression of LST8 with highest expression in brain and testis.
仅用于科研。不用于诊断过程。未经明确授权不得转售。
篇参考文献 (0)
生物信息学
蛋白别名: G beta-like protein; G protein beta subunit-like; GBL protein; Mammalian lethal with SEC13 protein 8; mLST8; mLST8 / mLST8; Protein GbetaL; Target of rapamycin complex subunit LST8; TORC subunit gable; TORC subunit LST8; TORC subunit WAT1; transducin (beta)-like 4
基因别名: 0610033N12Rik; AA409454; AI505104; AI851821; Gbl; Lst8; Mlst8
UniProt ID: (Mouse) Q9DCJ1, (Rat) Q9Z2K5
Entrez Gene ID: (Mouse) 56716, (Rat) 64226




